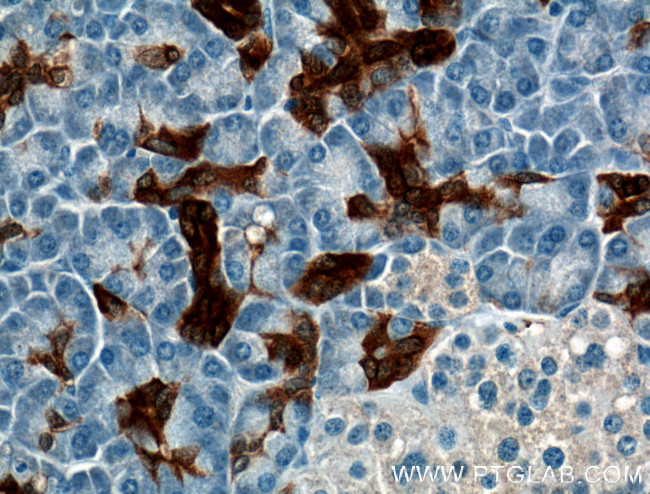
Annexin A3 Antibody in Immunohistochemistry (Paraffin) (IHC (P))

Search
Proteintech
Annexin A3 Monoclonal Antibody (1A11E4)
{{$productOrderCtrl.translations['antibody.pdp.commerceCard.promotion.promotions']}}
{{$productOrderCtrl.translations['antibody.pdp.commerceCard.promotion.viewpromo']}}
{{$productOrderCtrl.translations['antibody.pdp.commerceCard.promotion.promocode']}}: {{promo.promoCode}} {{promo.promoTitle}} {{promo.promoDescription}}. {{$productOrderCtrl.translations['antibody.pdp.commerceCard.promotion.learnmore']}}
产品信息
66405-1-IG
种属反应
宿主/亚型
分类
类型
克隆号
抗原
偶联物
形式
浓度
纯化类型
保存液
内含物
保存条件
运输条件
产品详细信息
Immunogen sequence: MASIWVGHR GTVRDYPDFS PSVDAEAIQK AIRGIGTDEK MLISILTERS NAQRQLIVKE YQAAYGKELK DDLKGDLSGH FEHLMVALVT PPAVFDAKQL KKSMKGAGTN EDALIEILTT RTSRQMKDIS QAYYTVYKKS LGDDISSETS GDFRKALLTL ADGRRDESLK VDEHLAKQDA QILYKAGENR WGTDEDKFTE ILCLRSFPQL KLTFDEYRNI SQKDIVDSIK GELSGHFEDL LLAIVNCVRN TPAFLAERLH RALKGIGTDE FTLNRIMVSR SEIDLLDIRT EFKKHYGYSL YSAIKSDTSG DYEITLLKIC GGD (1-322 aa encoded by BC000871)
靶标信息
This gene encodes a member of the annexin family. Members of this calcium-dependent phospholipid-binding protein family play a role in the regulation of cellular growth and in signal transduction pathways. This protein functions in the inhibition of phopholipase A2 and cleavage of inositol 1,2-cyclic phosphate to form inositol 1-phosphate. This protein may also play a role in anti-coagulation.
仅用于科研。不用于诊断过程。未经明确授权不得转售。
篇参考文献 (0)
生物信息学
蛋白别名: 35-alpha calcimedin; Annexin 3; Annexin A3; Annexin III; Annexin III (lipocortin III); annexin III (lipocortin III, 1,2-cyclic-inositol-phosphate phosphodiesterase, placental anticoagulant protein III, calcimedin 35-alpha); Annexin-3; Annexin3; ANXA 3; calcimedin 35-alpha; Inositol 1,2-cyclic phosphate 2-phosphohydrolase; Lipocortin III; PAP-III; Placental anticoagulant protein III
基因别名: ANX3; ANXA3
UniProt ID: (Human) P12429
Entrez Gene ID: (Human) 306